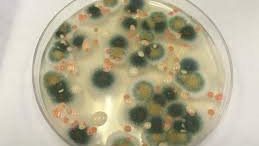
txt

يلقي الدكتور صابر عرب وزير الثقافة الأسبق، وعضو مجلس إدارة المجمع العلمي المصري محاضرة بعنوان الثقافة والتنمية في السادسة مساء يوم السبت ٢٩ أبريل الجاري في مقر المجمع بميدان التحرير بالقاهرة.
يأتي ذلك في إطار المحاضرات الشهرية هذا الموسم التي ينظمها المجمع العلمي المصري، وتتناول العديد من القضايا التي تتعلق بالتطور العلمي والثقافي في المجتمع.
يذكر أن الدكتور صابر عرب، هو أستاذ تاريخ العرب الحديث، وله العديد من المؤلفات العلمية القيمة، ورأس عددا من المؤسسات الثقافية، قبل أن يشغل منصب وزير الثقافة، وهو عضو في العديد من الهيئات العلمية في مصر وخارجها.
يرأس المجمع العلمي الدكتور فاروق اسماعيل، ويتولي الدكتور محمد الشرنوبي أمين عام المجلس، ويضم المجمع، الذي اسس منذ اكثر من مائتي عام، في عضويته العديد من الرموز العلمية والثقافية في المجتمع المصري في شتى المجالات.